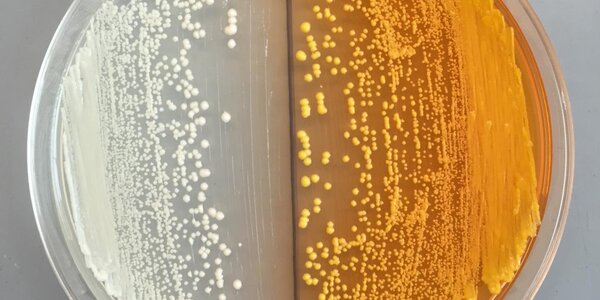
Article teaser image

Zeolite: New Chemical Structures Can Remove CO2 From Gas Mixtures
A newly discovered family of chemical structures known as zeolites could increase the value of biogas and natural gas that contains carbon dioxide.
The zeolites -- crystalline aluminosilicates with frameworks that contain windows and cavities the size of small molecules -- can separate out carbon dioxide more effectively from fuel gases than those previously known.
Existing zeolites have widespread use in industrial processes that involve gas separation and catalytic conversion, for example to remove nitrogen and carbon dioxide from compressed air to generate oxygen in hospitals and…